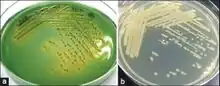

Aeromonas veronii
| Aeromonas veronii | |
|---|---|
| |
| Aeromonas veronii a) Rimler Shott agar, b) Trypticase Soy agar. | |
| Scientific classification | |
| Domain: | Bacteria |
| Phylum: | Pseudomonadota |
| Class: | Gammaproteobacteria |
| Order: | Aeromonadales |
| Family: | Aeromonadaceae |
| Genus: | Aeromonas |
| Species: | A. veronii |
| Binomial name | |
| Aeromonas veronii Hickman-Brenner et al., 1987 | |
| Synonyms | |
|
Aeromonas culicicola[1] | |
Aeromonas veronii is a Gram-negative, rod-shaped bacterium found in fresh water and in association with animals.[2] It can be a pathogen of humans and a beneficial symbiont of leeches. In humans A. veronii can cause diseases ranging from wound infections and diarrhea to sepsis in immunocompromised patients. Humans treated with medicinal leeches after vascular surgery can be at risk for infection from A. veronii and are commonly placed on prophylactic antibiotics.[3] Most commonly ciprofloxacin is used but there have been reports of resistant strains leading to infection.[4] In leeches, this bacterium is thought to function in the digestion of blood, provision of nutrients, or preventing other bacteria from growing.
A 2005 study showed the potential for using probiotics for controlling Streptococcus iniae infection in trout. This study used the gastrointestinal contents of rainbow trout to screen for bacteria that inhibited growth of S. iniae and Lactococcus garvieae. They identified A. veronii as a potential candidate for control of S. iniae and L. garvieae infections in aquaculture. A. veronii, given live in the feed, protected the trout when challenged with S. iniae or L. garvieae.[5]
References
- ↑ "Genus Aeromonas". List of Prokaryotic Names with Standing in Nomenclature. Archived from the original on 13 November 2022. Retrieved 16 November 2016.
- ↑ F. W. Hickman-Brenner; K. L. MacDonald; A. G. Steigerwalt; G. R. Fanning; D. J. Brenner; J. J. Farmer III (1988). "Aeromonas veronii, a new ornithine decarboxylase-positive species that may cause diarrhea". Journal of Clinical Microbiology. 25 (5): 900–906. doi:10.1128/JCM.25.5.900-906.1987. PMC 266114. PMID 3584425.
- ↑ Whitaker, Iain S.; Kamya, Cyril; Azzopardi, Ernest A.; Graf, Joerg; Kon, Moshe; Lineaweaver, William C. (2009-11-01). "Preventing infective complications following leech therapy: Is practice keeping pace with current research?" (PDF). Microsurgery. 29 (8): 619–625. doi:10.1002/micr.20666. ISSN 1098-2752. PMID 19399888. S2CID 19575531. Archived from the original (PDF) on 2018-11-01. Retrieved 2021-06-27.
- ↑ Patel, Ketan M.; Svestka, Michael; Sinkin, Jeremy; Ruff, Paul (January 2013). "Ciprofloxacin-resistant Aeromonas hydrophila infection following leech therapy: A case report and review of the literature". Journal of Plastic, Reconstructive & Aesthetic Surgery. 66 (1): e20–e22. doi:10.1016/j.bjps.2012.10.002. PMID 23084650.
- ↑ Brunt J, Austin B (2005). "Use of a probiotic to control lactococcosis and streptococcosis in rainbow trout, Oncorhynchus mykiss (Walbaum)". Journal of Fish Diseases. 28 (12): 693–701. doi:10.1111/j.1365-2761.2005.00672.x. PMID 16336470.
External links
- Type strain of Aeromonas veronii at BacDive - the Bacterial Diversity Metadatabase Archived 2016-05-31 at the Wayback Machine